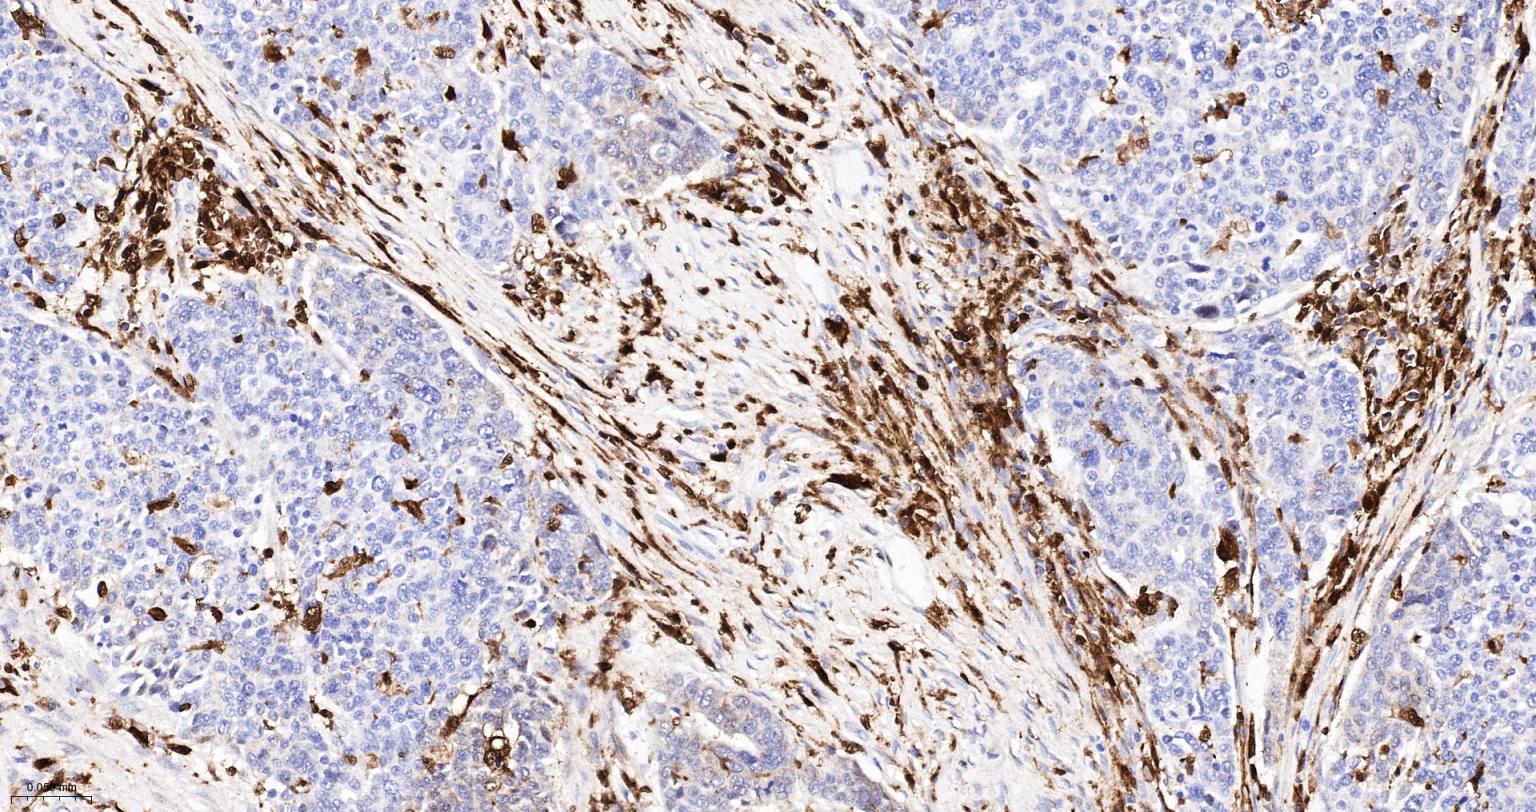
CD16 Recombinant Rabbit mAb(bs

相关产品推荐更多 >

CD68 Rabbit pAb, APC conjugated(bs-1432R-APC)-100ul
¥2980
IDH3G Rabbit pAb, APC-Cy5.5 conjugated(bs-15539R-APC-Cy5.5)-100ul
¥2980
NARFL Rabbit pAb, BF680 conjugated(bs-19019R-BF680)-100ul
¥2980
CA9 Rabbit pAb, BF405 conjugated(bs-4029R-BF405)-100ul
¥2980
phospho-Androgen Receptor (Ser578) Rabbit pAb, BF647 conjugated(bs-0943R-BF647)-100ul
¥2980
万千商家帮你免费找货
0 人在求购买到急需产品
- 详细信息
- 文献和实验
- 技术资料
- 应用范围:
产品信息以Bioss网站为准
- 规格:
25ul/50ul
| 规格: | 25ul | 产品价格: | ¥800.0 |
|---|---|---|---|
| 规格: | 50ul | 产品价格: | ¥1400.0 |
| 产品编号 | bsm-54679R |
| 英文名称 | CD16 Recombinant Rabbit mAb |
| 中文名称 | FC段γ受体3/免疫球蛋白G Fc段受体III重组兔单抗 |
| 英文别名 | FCG3A_HUMAN; Low affinity immunoglobulin gamma Fc region receptor III-A; CD16a antigen; Fc-gamma RIII-alpha; Fc-gamma RIII; Fc-gamma RIIIa; FcRIII; FcRIIIa; FcR-10; IgG Fc receptor III-2; CD_antigen: D16a; FCGR3A; CD16A; FCG3; FCGR3; IGFR3. |
| 产品应用 | ICC/IF=1:100-500, Flow-Cyt=1:100-200, IHC-P=1:200-2000, IHC-F=1:200-2000, IF=1:200-2000 Not yet tested in other applications. |
| 交叉反应 | Human, Rat |
| 抗体来源 | Rabbit |
| 免疫原 | A synthesized peptide derived from human CD16 |
| 亚型 | IgG |
| 性状 | Liquid |
| 纯化方法 | affinity purified by Protein A |
| 克隆类型 | Recombinant |
| 理论分子量 | 27 kDa |
| 浓度 | 1mg/ml |
| 储存液 | 0.01M TBS (pH7.4) with 1% BSA, 0.02% Proclin300 and 50% Glycerol. |
| 研究领域 | Immunology > Cell Type Markers > CD > NK Cells Stem Cells > Hematopoietic Progenitors > Hematopoietic Stem Cells > Human Lineage Negative Stem Cells > Hematopoietic Progenitors > Lymphoid > NK Cell Lineage Stem Cells > Hematopoietic Progenitors > Myeloid > Monocytic Lineage Stem Cells > Hematopoietic Progenitors > Myeloid > Neutrophil Lineage |
| 亚基 | Exists as a heterooligomeric receptor complex with Fc epsilon receptor I gamma subunit and / or the CD3 zeta subunit. Interacts with INPP5D/SHIP1. |
| 亚细胞定位 | Cell membrane. Secreted. Exists also as a soluble receptor. |
| 组织特异性 | Expressed on natural killer cells, macrophages, subpopulation of T-cells, immature thymocytes and placental trophoblasts. |
| 翻译后修饰 | Glycosylated. Contains high mannose- and complex-type oligosaccharides. The soluble form is produced by a proteolytic cleavage. [MISCELLANEOUS] Encoded by one of two nearly indentical genes: FCGR3A (Shown here) and FCGR3B which are expressed in a tissue-specific manner. The Phe-203 in III-A determines the transmembrane domains whereas the 'Ser-203' in III-B determines the GPI-anchoring. |
| 相似性 | Contains 2 Ig-like C2-type (immunoglobulin-like) domains. |
| 功能 | Receptor for the Fc region of IgG. Binds complexed or aggregated IgG and also monomeric IgG. Mediates antibody-dependent cellular cytotoxicity (ADCC) and other antibody-dependent responses, such as phagocytosis. |
| 保存条件 | Shipped at 4℃. Store at -20℃ for one year. Avoid repeated freeze/thaw cycles. |
| 注意事项 | This product as supplied is intended for research use only, not for use in human, therapeutic or diagnostic applications. |
| 背景资料 | This gene encodes a receptor for the Fc portion of immunoglobulin G, and it is involved in the removal of antigen-antibody complexes from the circulation, as well as other responses, including antibody dependent cellular mediated cytotoxicity and antibody dependent enhancement of virus infections. This gene (FCGR3A) is highly similar to another nearby gene (FCGR3B) located on chromosome 1. The receptor encoded by this gene is expressed on natural killer (NK) cells as an integral membrane glycoprotein anchored through a transmembrane peptide, whereas FCGR3B is expressed on polymorphonuclear neutrophils (PMN) where the receptor is anchored through a phosphatidylinositol (PI) linkage. Mutations in this gene are associated with immunodeficiency 20, and have been linked to susceptibility to recurrent viral infections, susceptibility to systemic lupus erythematosus, and alloimmune neonatal neutropenia. Alternatively spliced transcript variants encoding different isoforms have been found for this gene. [provided by RefSeq, Aug 2020] |
| 应用 | 推荐稀释比例 |
| {ICC/IF} | {1:100-500} |
| {Flow-Cyt} | {1:100-200} |
| {IHC-P} | {1:200-2000} |
| {IHC-F} | {1:200-2000} |
| {IF} | {1:200-2000} |

风险提示:丁香通仅作为第三方平台,为商家信息发布提供平台空间。用户咨询产品时请注意保护个人信息及财产安全,合理判断,谨慎选购商品,商家和用户对交易行为负责。对于医疗器械类产品,请先查证核实企业经营资质和医疗器械产品注册证情况。
文献和实验[IF={{ 3.6 }}] {Seung-Wan Hong. et al. The Effect of Pregabalin on Microglia Differentiation in Rat with Neuropathic pain: A Preliminary Study. INT J MED SCI. 2024; 21(7): 1265–1273} {IF} {Rat}
技术资料暂无技术资料 索取技术资料





